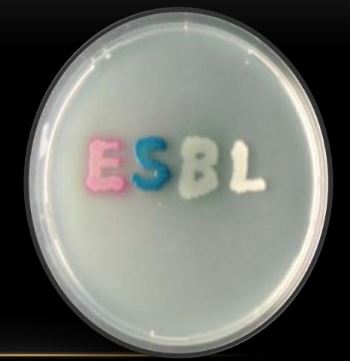

Category Journal paper

The post-antibiotic era: A case study
Published in the latest issue of the MJA is a case study of a Victorian patient diagnosed with a carbapenem-resistant Klebsiella pneumoniae. The patient, from rural Victoria, had no history or recent overseas travel and no hospital contact for the last 15 years. He was transferred to a metropolitan hospital for intensive care for severe […]

What is the best way to treat skin abscess?
Skin (staphylococcal) abscesses (boils) are often treated with antimicrobials, but are they really needed? The New England Journal of Medicine recently presented a case vignette and asked prescribers to weigh in on whether they thought antibiotics were needed or if incision and drainage alone were enough.

Revised sepsis definitions are a scene changer!
These carefully wrought new definitions potentially revolutionise our approach and will provide greater diagnostic clarity for more rapid recognition and treatment. Highly relevant to all clinicians. Recommendations (JAMA current edition) Editorial and several other items of note (all free access) Sepsis should be defined as life-threatening organ dysfunction caused by a dysregulated host response to infection. For […]

Sparing meropenem 101 – treatment of ESCPM species and AmpC betalactamases unpacked
Guest post: Patrick Harris, Staff Specialist in Microbiology, Central Laboratory, Pathology Queensland, Brisbane Infectious disease and microbiology trainees diligently learn about organisms that have a type of broad-spectrum beta-lactamase (i.e. an enzyme that can inactivate betalactam antibiotics) called ‘AmpC’. These enzymes are encoded by a gene that is usually located on the chromosome of many Gram-negative […]

How to select an antibiotic dose for children
Dosing information for children, unlike adults, is often presented as a mg/kg range. So how do you choose what dose to use?This recent discussion from the BMJ has some important take home messages . Did you know that a child qualifies for an adult antibiotic dose usually by the time they weigh 40 kg? That […]

Recurrent urinary tract infection in women – are antibiotics the answer?
What is the evidence? This interesting paper from 2010 discusses the natural history of UTI in women and distinguishes two conditions – the ‘urethral’ (or ‘dysuria/frequency’) syndrome’ (US) which affects a proportion of women with recurrent symptoms and many courses of treatment. It is known that US is a self-limited condition in a majority of patients. Some women are said to […]
Reducing ESBL Gram negative fluoroquinolone resistance – what is the ecological sweet spot for usage?
This excellent recent paper from Sarma et al brings focus on what the target level of quinolone use should be in order to have an impact on quinolone resistance in Enterobacteriaceae. It describes the situation across a region of England (9 hospitals and other facilities) where quite stringent control of cephalosporin use was already in place […]
Case report: Community-Acquired Pyelonephritis in Pregnancy Caused by KPC-Producing Klebsiella pneumoniae
In northern NSW, we already face cases similar to that described below – infection with multi-drug resistant carbapenemase-producing Gram negative organisms. The major global types of these organisms are named with acronyms that refer to the type of carbapenemase gene – KPC, NDM (New Delhi Metallobetalactamase), IMP (imipenemase) and others. KPC-type organisms are prevalent in Greece, […]
Diagnostic error is a major factor leading to inappropriate antimicrobial use- recent landmark paper
Diagnostic accuracy is a factor neglected by most antimicrobial stewardship programs and should perhaps be subject to regular audit and feedback. It is heavily dependent upon the context of the clinical contact – for example, time-pressured, after hours hospital ward patient encounters are prone to quick judgements and sloppy diagnoses. For a persuasive discussion of […]
Managing Paediatric Sepsis
Managing paediatric sepsis is difficult. Children require different drugs and doses and the typical pathogens vary across age groups. The team at the BMJ have put together a review of the management and treatment options for children, including neonates. Antibiotics are the only treatment of proven value in paediatric sepsis. Progression to organ failure and shock can be rapid […]